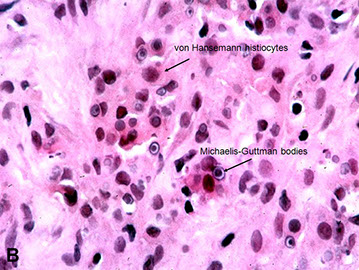

Ureter
Bladder
Urothelial carcinoma
Urothelial (transitional cell) tumors
- Squamous differentiation
- Glandular differentiation
- Papilloma
- Inverted papilloma
- PUNLMP
- Papillary urothelial carcinoma
- Carcinoma in situ
- Invasive urothelial carcinoma
Ureter
Fibroepithelial Polyp
Almost exclusively in males, B9, Rare, tend to occur in kiddos and adolescents, rarely in adults, usually presents c urinary retention, bladder outlet obstruction and/or hematuria
- usually seen in the ureter or urethra, rather than the bladder
Gross: polypoid excrescence
Micro: "clover leaf-like" projections, lined by normal-appearing urothelium
Tx/Px: do not recur after excision, not assoc c cancer
DDx: urothelial papilloma (does not have lining of normal epithelium) - misdiagnosing a fibroepithelial polyp in a younger pt as a urothelial papilloma in a younger pt would subject them to years of unnecessary close surveillance
- may also consider florid cystitis cystica et glandularis, polypoid / papillary cystitis, and inverted papilloma
Reference:
http://apps.pathology.jhu.edu/sp/week-1-case-1-1112/
Fibroepithelial polyp


Urothelial Ca
How to differentiate Urothelial ca from Prostate ca?
A panel of PSA, HMWCK, and p63 was optimal for separating
95% PCa (PSA+/HMWCK and/or p63–)
vs 97% UCa (PSA–/HMWCK and/or p63+)
The majority of PCa cases retain PSA
Negative PSA with positive HMWCK and/or p63 establishes a diagnosis of UCa.
CK7/CK20 coexpression was noted in 50% of UCa cases, whereas 86% of PCa cases were negative with both
Poorly Differentiated Prostatic Carcinoma (PCA) vs. Urothelial Carcinoma (UC) (Epstein et al. Am J Surg Pathol 2014)

Bladder
Acute Cystitis
neuts in lamina propria and urothelium
- assoc c edema of lamina propria and freq urothelial denudation
-- be careful for denuded CIS!!!
Ulcerative Cystitis
Suppurative Membranous Cystitis
Emphysematous Cystitis
Viral Cystitis
Fungal Cystitis
Actinomycosis
Chronic Cystitis
Papillary Polypoid Cystitis
- aka Proliferative Papillary Cystitis
hx of catheter or vesicular fistula, mostly in dome or posterior wall
- designation of papillary cystitis used when thin, finger-like papillae are present
- polypoid cystitis used c edematous and broad-based papillae
Micro: broad papillary projections of inflamed lamina propria c overlying hyperplastic urothelium
- superficial umbrella cells invariably present
- prominent stromal edema, congestion and inflam infiltrate
Follicular Cystitis
usually incidental finding; assoc c infx, bx or BCG tx
Micro: can have normal or finely nodular appearance by cystoscopy
- subepithelial lymphoid follicle c germinal center
Encrusted Cystitis
assoc c infx of urea-splitting bacteria in alkalinized urine
- ulcers coated c calcium and phosphate salt, mononuclear cell infiltrate and foreign body giant cell rxn
- may extend to muscularia propria
Granulomatous Cystitis
Bacteria, fungi, parasites, chemorads, malakoplakia
- F>M, present c sx of UTI, recurrent fever, hematuria, pturia, urgency, pain
Treatment-Induced Cystitis
BCG-Induced
Post-Surg Granuloma
Radiation Cystitis


Radiation Cystitis
May be misinterpreted as SCC
- may develop decades after radiation tx
Micro: Fibrin deposits assoc c hemorrhage and reactive epithelial prolif into lamina propria
- nests can have squamoid appearance and nuclear pleomorphism
Cytoxan-Induced Hemorrhagic Cystitis
in up to 8% of pts tx'd, secondary to toxic metabolite acrolein (an aldehyade and oxidizing agent)
- appears as diffuse severe hyperemia c edema and erosion or ulceration of mucosa
Micro: lamina propria c edema and extensive hemorrhage
- regeneration changes can be seen, be careful if calling CIS
Special Variants
Interstitial Cystitis
uncommon dx made on sx and cystoscopy
Scattered petechial hemorrhage and wedge-shaped ulceration (Hunner ulcer) showing petechial hemorrhage
- characteristic hlomerulations (mucoasl hemorrhage) and mucosal rupture
- mast cell infiltration in lamina propria and muscularis propia is common
- perineural mononuclear infiltrate also common
- fibrosis of lamina propria
Eosinophilic Cystitis
Assoc c allergic disorders, may have peripheral inc eos
- resolves spontaneously; sx are variable
Urethral Caruncle
Small nodular pedunculated erythematous lesion i post or lateral distal urethral wall, in elderly femmales
- look like small hemangiomas c mixed inflam
Micro: overlying epithelium hyperplastic
- IgG4+
- +/- pseudocarcinomatous epithelial hyperplasia
Polyomavirus Infx
- aka BK virus
DNA virus, a papomavirus (papilloma, polyoma, vacuolating SV-40 family)
Cells can resemble urothelial CIS
- pts usually immunocompromised
Micro: Large dark nuclei, can have smudgy inclusion c thick nuclear membrane, coarse reticulated chromatin
- Decoy cells - mimic CIS
- Comet cells - have short cytoplasmic tails
DDx: CMV, cancer
von Brunn Nest Proliferation
Seen in 85% of autopsy pts
- are a normal variant of bladder mucosa
- solid nests of urothelium that project into lamina propria
- have luinal eosinophilic secretions
- exuberant von Brunn nest prolif can be seen, that mimicks inverted appilloma or inverted UC
Cystitis Glandularis
Common histologic finding
- seen MC in trigone
2 types:
1) usual type
2) intestinal type (cystitis glandularis c intestinal metaplasia)
- less freq and MC in pts c exstrophy, lined by cells c mucinous epithelium and closely resembles colonic epithelium, stroma can have edema or hyalinized c inflam, glands are ordered and lack atypia or glands floating in mucinous pools
Usually merges c von Brunn nests in lamina propria
- when nests become cystic c central lumen formation and polarization of inner cells, term called cystitis glandularis used
Florid Cystitis Glandularis
one of the MC cancer mimics
- pts present c irritative sx or hematuria
- involvement of von Brunn nests by glandular metaplasia in exuberant prolif of glands lined by tall columnar cells c basally located nuclei
- extravasation of mucin into stroma
Endometriosis
One of the MC organs affected
- usually in women of reproductive age, approx 1% of women c endometriosis have urinary bladder involvement
- up to 1/2 have hx of pelvi surgery, may see a palpable pelvic mass in 1/2 of pts
- can be seen in men c prostate carcinoma treated c estrogen therapy
- sx include frequency, dysuria, and hematuria
- complications include obstruction of ureteric orifices c secondary hydronephrosis or vesicocolic fistula
Micro: made of endometrial glands and stroma c hemosiderin deposition
- glands lined by cuboidal cells c eosinophilic cytoplasma and pseudostratified nuclei that can have mits
IHC: (+) PAX8, ER, PR
Endocervicosis
Seen in women of reporoductive age that complain of suprapubic pain, dysuria, freq and hematuria c catamenial exacerbation of sx
- mimics adenocarcinoma
Predisposition of posterilor wall or post dome, usually in muscularis propria
Young women of reproductive age with bladder symptoms
Gross: Mass on the posterior wall or posterior dome of bladder
Micro: Irregular, haphazard endocervical-type glands within the muscular wall. Rarely associated with endometriotic stroma. Minimal nuclear atypia. May be associated with rupture of glands, resulting in extravasation of mucin
Differential diagnosis: Minimal deviation adenocarcinoma
Px: B9. Reported cases have had an uneventful postoperative course.
IHC(+) PAX8, ER, PR
Mullerianosis
In women of rep age
- common in posterior wall and can form tumor-like mass
Malakoplakia
Can be seen in any part of the GU tract, most commonly in the urinary bladder
- means "soft plaque" in Greek
Gross: Solitary or confluent yellow mucosal nodules or plaques
Micro: Mixed inflam; Epithelioid histiocytes with eosinophilic cytoplasm.
Michaelis-Guttman bodies - Basophilic, targetoid cytoplasmic inclusions, are lysosomes c degradation products of E. coli.
Michaelis-Gutmann bodies - large numbers of epithelioid histiocytes c abundant eosinophilic cytoplasmic inclusions, concentric laminated bodies that are PAS+
- concentrically laminated structure on EM
Malakoplakia
Arrows show Michaelis-Guttman bodies

Fibroepithelial Polyp
Almost exclusively in males, B9, Rare, tend to occur in kiddos and adolescents, rarely in adults, usually presents c urinary retention, bladder outlet obstruction and/or hematuria
- usually seen in the ureter or urethra, rather than the bladder
Gross: polypoid excrescence
Micro: "clover leaf-like" projections, lined by normal-appearing urothelium
Tx/Px: do not recur after excision
Nephrogenic adenoma
Clinical: Wide age range of presentation (usually middle-aged men) , ~1/5 occur in peds and some after kidney transplant
- Majority of cases associated with a history of genitourinary procedure, trauma, or calculi. Not a true neoplasm.
- Represents a metaplastic process
Micro: Composed of cuboidal cells with tubulo-cystic and papillary growth pattern. Scant cytoplasm
- lined by single layer columnar or cuboidal hobnail or flattened cells
- Minimal nuclear atypia and mitotic activity. In contrast, clear cell carcinomas have solid and diffuse growth pattern, ample portions of clear cytoplasm (positive for glycogen on PAS stain), significant
nuclear atypia and increased mitotic activity.
IHC: (+) PAX8, P504 (AMACR)
Px: may recur, but malignant transformation has not been seen
Nephrogenic Adenoma


Papillary and polypoid cystitis
Wide age range of presentation. Often associated with an indwelling catheter or colovesical fistula. On cystoscopy, can be confused for a neoplasm
Micro: Finger-like papillae or broad-based polypoid excrescences, lined by normal urothelium. Underlying lamina propria contains chronic inflammatory cells and ectatic vessels.
Postoperative spindle cell nodules/
pseudosarcomatous fibromyxoid tumor
Can be seen throughout the GU tract, including urinary bladder and prostate. May be seen spontaneously or following GU instrumentation or trauma. Represents a reparative/reactive process
Micro: Composed of a proliferation of (myo)fibroblasts. Uniform nuclear features. Variable mitotic activity.
DDx:: leiomyosarcoma.

[1]


Urothelial neoplasms [WHO classification]
1) Flat lesions
• Urothelial carcinoma in situ: variety of growth patterns including clinging and cancerization/pagetoid involvement
2.) Papillary neoplasms
a. Includes papilloma, inverted papilloma, papillary neoplasm of low malignant potential, low-grade and high-grade papillary carcinoma.
b. Noninvasive versus invasive. If the latter is present, the extent of invasion has therapeutic implication, ie, lamina propria versus muscularis propria.
c. Variants of invasive TCC include sarcomatoid (carcinosarcoma), microscystic and micropapillary
Urothelial Carcinoma -- Two Phenotypes?
Non-muscle invasive BC (NMIBC) 70-80%
Muscle Invasive BC (MIBC) 20-30%

Genes in bladder ca, (Netto, LASOP 2021)

Reactive Urothelial Atypia
• Acute or chronically inflamed urothelium
• Vesicular uniformly enlarged nuclei with central
prominent nucleoli.
• Mitotic figures may be common.
• History of instrumentation, infection, stones, therapy
- Overuse of the diagnosis “mild dysplasia”
Mild staining and fixation alterations
Normal vs. mild dysplasia
Urologists desensitized to the diagnosis of
dysplasia
Do not use the term “mild dysplasia” – diagnose
as “normal or reactive”

Reactive urothelium (Dr. Epstein)
Reactive urothelium

More reactive urothelium

Squamous cell carcinoma
Uncommon except where Schistosomiasis is endemic, ie, Middle East.
- Verrucous carcinoma is a rare variant of squamous cell carcinoma. Associated with an indolent behavior.
Small cell undifferentiated carcinoma
Histologically, similar to the oat-cell carcinoma of lung. Often associated with urothelial CIS or invasive TCC.
- May be assoc c paraneoplastic syndromes, including hypercalcemia and SIADH.
Lymphoepithelial-like carcinoma
• Micro: Undifferentiated cells with syncytial growth pattern, accompanied by significant numbers of small lymphocytes. May be seen alone or in association with invasive TCC.
DDx: lymphoma.
Paraganglioma
Sx include sustained or paroxysmal hypertension.
Micro: Classic nesting growth pattern (zellballen).
IHC: S100-positive sustentacular cells
Histologic features of papillary dz

Urothelial Papilloma
Usually solitary lesions, 1-2% of papillary lesions, present c hematuria (gross or microscopic), MC in young adults
- can have extensive multifocal involvement of mucosa, called diffuse papillomatosis
- papillomas are diploid and have frequent FGFR3 (3/4) mutation
• Discrete papillary growth with a central fibrovascular core lined
by urothelium of normal thickness and cytologic features
• No need to count cell layers (7)
• Very rare lesion
Micro: exophytic papillary neoplasm lined with normal appearing urothelium, lacking significant atypia
- architecturally are slender with minimal branching
- superficial umbrellas can be prominent and can have vacuolization and large multinucleated cells
Tx: excision
Px (Magi-Galluzzi et al. Am J Surg Pathol 2004)
•34 de novo papillomas
•Mean age 58 years
•24 males; 10 female
• F/U in 26 pts (mean 29 months)
• 3/34 (8.8%) recurrence rate
• 3/34 (8.8%) progression to LG UrCa or PUNLMP
• No progression to invasive UrCa (pT1 or pT2)
urothelial papiloma



Flat Urothelial Hyperplasia
can be adjacent to LG papillary tumors (not malig if isolated lesion)
- do not need to be tx'd
Papillary Urothelial Hyperplasia
Controversial, has normal-appearing urothelium 4-7 cells thick
Micro: has undulating folds that can have inc vascularity at base
DDx: papilloma (is more finely arborizing)
Pseudocarcinomatous Epithelial Hyperplasia
Assoc c chemorads
Micro: Pseudoinfiltrative nests of epithelium adjacent to ectatic BV and c fibrin thrombi
Flat Urothelial Lesions c Atypia
1) Reactive Urothelial Atypia
-usually in setting of chronic irritation (instrumentation, rads, chemo)
Micro: acute or chronic inflam urothelium, mits can be seen and frequent
2) Urothelial Atypia of Unknown Significance
spectrum that may or not be attributed to inflam alone, but falls below limit of dysplasia
- no adverse outcome on follow up
3) Urothelial Dysplasia
• Preneoplastic atypia short of CIS
M>F, avg age 60 yo, presents c irritation or obstructive sx or hematuria;
- rare, Relatively uncommon diagnosis – most cases
either normal or significant atypia (CIS)
- strong risk factor for CIS and invasive ca (~15%)
- secondary dysplasia assoc c concurrent or prior hx of urothelial ca, and is risk for recurrence
- Without qualifier, equals “moderate dysplasia”
Micro: abnormal architectural and cytologic changes that fall short of unequivocal CIS
- see altered polarity of superficial cells and cytoplasmic clearing is common
- cells vary in size and shape and nuclei c irreg granular chromatin and wrinkled nuclear membranes
- nuclear crowding and hyperchromasia
- long axis of nuclei are parallel to BM, lack prominent nuclei or atypical mits
Grading of dysplasia is NOT recommended
Management of Urothelial Dysplasia
• In someone with h/o of CIS, indicates the disease is
recurring. May be treated with intravesical therapy
• In someone with de novo diagnosis of dysplasia,
often patients followed more closely for CIS

Urothelial dysplasia



CIS

Use of immunohistochemical stain in diagnosis of urothelial carcinoma in situ (CIS). Urothelial CIS (A) shows full-thickness CK20 (B) and p53 (C) overexpression [1]

[1]
4) Urothelial CIS
Elderly men (60-70 yo), 10M>1F, usually assoc c concurrent of prior UC, presents c irritative or obstructive sx or hematuria
- can masquerade as interstitial cystitis
- cystoscopy can show nonspecific or velvety erythematous lesion c granular or cobblestone appearance
- usually in trigone and base of bladder
Presence of cytologically malignant cells regardless of
quantity
Micro: Full thickness invovement is NOT a prerequisite
- disordered prolif of malig urothelial cells c loss of polarity and dec cellular cohesion
- high NC, nuclear pleomorphism, hyperchromasia,, irreg nuclear membranes and irreg mits
• No need to be full thickness
• Pagetoid cells
• Spectrum of atypia and cell size
• Umbrella cell layer may still be present
• CIS cells 5x size of stromal lymphocytes, compared to normal
cells which are 2x size of lymphocytes
• Enlarged & hyperchromatic ON 10X OBJECTIVE
• Dyscohesive : “denuding cystitis”
• Prostatic Urethra: Caution !
Variants: large and small cell, denuding (frequently missed! Loses cell adhesion molecules), Pagetoid, Sq, glandular, micropapillary, microinvasion (CISmic)
Genes: p53 and RB genes are the MC altered genes
Reactive vs CIS by IHC

Urothelial (transitional cell) tumors
- high morbidity and mortality (bladder tumors in general)
- 90% of all bladder tumors; MC morphology (which may lead to invasive TCCa) is noninvasive papillary tumors, then flat urothelial carcinoma (aka CIS)
Subtypes:
Squamous differentiation
Glandular differentiation
Variant histology
Nested urothelial carcinoma
- variant of urothelial ca originally recognized by its ability to mimic b9 conditions like proliferating von Brunn nests, esp in small bx's
- however, has a propensity to invade deep into bladder wall despite its low-grade morphology
- may be assoc c carcinoma in situ or conventional urothelial ca
- IHC: similar to typical UC (+ CK7 and p63, often CK20+)
Nested urothelial carcinoma [2]

Papillomas
<1% of bladder tumors
- MC in younger pts
Micro: Fibrovasc cores are surrounded by normal-looking transitional epithelium
Inverted papilloma


Inverted papilloma
Rare, b9 urothelial tumor, presents c hematuria and irritative sx
- 7M.1F, usually ~50 yo
- usually trigone and bladder neck
- b9 and not related to urothelial carcinoma
• Most commonly seen in the trigone region
• Usually solitary (3%
• Polypoid /sessile on cystoscopy , smooth surface
• Size: wide range
• Can be associated with urothelial carcinoma, yet not
thought to be directly related
Micro: smooth surface covered by normal urothelium and endophytic growth of urothelial cells aroborizing extensively from surface urothelium to lamina propria
- anastomosing cord, columns and thin trabecula
- peripheral pallisading with spindly nuclei
- no atypia or mits
- no exophytic component
- may see squamous morules
- may show non-keratinizing squamous metaplasia
DDx: inverted urothelial carcinoma
Inverted Papilloma Comparison to Urothelial Carcinoma
• Lacks cytological atypia
• Mitotic activity limited to basal cell layer
• Lacks inflammation and reactive stroma
• Squamous metaplasia lacks keratin formation
• Lacks muscularis propria invasion
Px: recurrence ~1%


Inverted papilloma


Urothelial Papillary Proliferation of Undetermined Significance
(UPUMP)?
• Tented or undulated thickened urothelium WITHOUT
SIGNIFICANT ATYPIA
• Base with dilated capillaries
• No discrete papillary fronds
• UPMP is frequently associated with prior or concurrent low
grade papillary neoplasms:
- papilloma
- PUNLMP
- low grade papillary urothelial carcinoma
• De novo diagnosis: close follow up
• Follow up for papillary tumors: could represent shoulder
lesion of recurrent tumor

UPUMP

Papillary Urothelial Neoplasms of Low Malignant Potential (PUNLMP)
Described in 2004 WHO as papillary neoplasm c feature bwt b9 papilloma and low-grade papillary utoherlial carcinoma
- show minimal mits and minimal nuclear atypia
- architectural complexity low
- may have minimal nuclear atypia and thickening
• Orderly arrangement
• Thicker than papilloma
• No atypia , at most nuclear enlargement
• At most rare mitoses at base
• Not associated with invasion
Px: have low but real risk of recurrence, and require clinical surveillance
Involvement of FGFR-3 and HRAS are important for the development of low-grade carcinomas
- p53 and RB are involved in progression to high-grade neoplasms and carcinoma in situ
-- p16 may be involved, typically as a deletion of the locus in FISH assays


punlmp


Papillary urothelial carcinoma
Terminology of Papillary Tumors (LASOP Netto lecture 2021)
• Non invasive papillary carcinoma, Low grade
• Non invasive papillary carcinoma , High grade
• Do Not use: “In situ papillary urothelial carcinoma”
• Non invasive papillary urothelial carcinoma
• Invasive papillary urothelial carcinoma
• Grade by the worst component
• •? HG component <
- Low grade: appears orderly with a thicker lining than papillomas c a little nuclear atypia and few mits
--- ~10% invade
- assoc c Fibroblast growth factor receptor 3 (FGFR3), esp in non-muscle invasive tumors
- High grade: marked atypia, dyscohesive, large hyperchromatic nuclei, lots of mits
~80% invade
Non Invasive Papillary Carcinoma, Low Grade
• Overall orderly arrangement with minimal variation in polarity
(clonal)
• On low power looks “pink” due to low N/C ratio
• Mild atypia consisting of scattered enlarged hyperchromatic
nuclei
• Scattered mitotic figures some at levels higher than base layer
• Inconspicuous nucleoli
Non Invasive Papillary Carcinoma, High Grade
• Overall disorderly arrangement with irregularly
clustered cells, fused papillae
• Marked atypia analogous to CIS
• Numerous mitotic figures including atypical forms at
all levels
• Dyscohesive single cells
• Prominent nucleoli
Invasive urothelial carcinoma
Must be staged:
Noninvasive, papillary = Ta; CIS = Tis; Lamina propria invasion = T1; Invasion of adjacent structures = T4
Lamina Propria Invasion
Inverted growth vs true invasion:
Small nests
Retraction artifact
Paradoxical differentiation/maturation
Substaging
Focal vs. extensive
Depth relative to muscularis mucosae (LAM1 vs. LAM2)
Micrometer (1.5 MM)
Maximum length of invasive foci
Terminology - Muscle
• Muscularis propria (detrusor muscle) invasion
• Muscularis mucosae invasion (do not report?)
• Do not use “superficial muscle” or “deep
• Do not use “superficial bladder
Muscularis Propria (MP) Invasion
• Infiltration of thick muscle bundles
• If uncertain MP vs. MM indicate uncertainty to urologist
• Do not attempt to substage MP invasion
• Fat seen at all levels, such that does not
indicate extension out of the bladder
Micropapillary variant of invasive urothelial carcinoma asspc c high pathologic stage and lymph node mets 2/2 inc rate of lymphovascular invasion
*** CAVEAT: non-invasive papillary urothelial carcinomas can have a micropapillary-like pattern, and these tumors have a clinical course and prognosis similar to HG-noninvasive papillary urothelial ca. Thus the designation of "micropapillary" variant should be restricted to only INVASIVE carcinomas to avoid unnecessary tx [2]
Non Invasive Papillary Carcinoma, Low Grade

Non Invasive Papillary Carcinoma, Low Grade

Non Invasive Papillary Carcinoma, High Grade

Micropapillary variant of urothelial carcinoma is the presence of lacunae around invading nests


Micropapillary variant should only be diagnosed when definitely invasive [2]
Non Invasive Papillary Carcinoma, High Grade

Non Invasive Papillary Carcinoma, High Grade



Inverted Urothelial Carcinoma
Has cytologic atypia, co-existing exophtic papillary component, stromal invasion, frequent mits
IHC: high p53 and Ki67
- (+) CK20 expression
Genes: Urovysion FISH positivity
-urovysion can be performed on any type of urine specimen, including bladder washing and ureter washings
-- Polyomavirus infx may cause abnormal findings and cause a positive test
-- cells with abnormal cytomorphology should be closely evaluated, as they are likely to cause abnormal test results
Plasmacytoid Variant Urothelial Carcinoma
Micro: Malignant cells dyscohesive with eccentric nuclei and glassy eosinophilic cytoplasm and signet-ring morphology
Px: assoc c extensive spread through bladder wall and abdominal cavity compared to other variants of urothelial ca
- thus has uniformly poor px with advanced stage at presentation and metastatic dz progession
Plasmacytoid variant of urothelial carcioma [2]

Adenocarcinoma
Malignant tumor making up to 1/50 bladder tumors
- M>F, assoc c nonfunctional bladder or exstrophy usually presenting c hematuria
Micro: malignant-looking glands that make mucin
- can be subclassified into mucinous, enteric or signet ring varieties
IHC: similar to colonic AC, (+) CK20, p63, CK5/6, B-catenin (cytoplasmic)
- variable CK7 and CDX2
- B-catenin is NUCLEAR positive in colonic ac and CYTOPLASMIC in the bladder, can be an important differentiation!
To differentiate urothelial carcinoma and prostate carcinoma, urothelial carcinoma is usually positive for HMWK and nuclear p63, while these markers are positive in basal cells of b9 prostate glands, their expression is lost in prostatic adenocarcinoma
Urothelial carcinoma is negative for PAX-8
Tx: surgery, rads and chemo depending on stage
Px: poor
AC of the bladder


References
1. Xiao X et al. Practical Applications of Immunohistochemistry in the Diagnosis of Genitourinary Tumors. Arch Pathol Lab Med. 2017; 141:1181-1194
2. Wang. Urinary Bladder Pathology: WHO and AJCC Staging Update. July 2018
